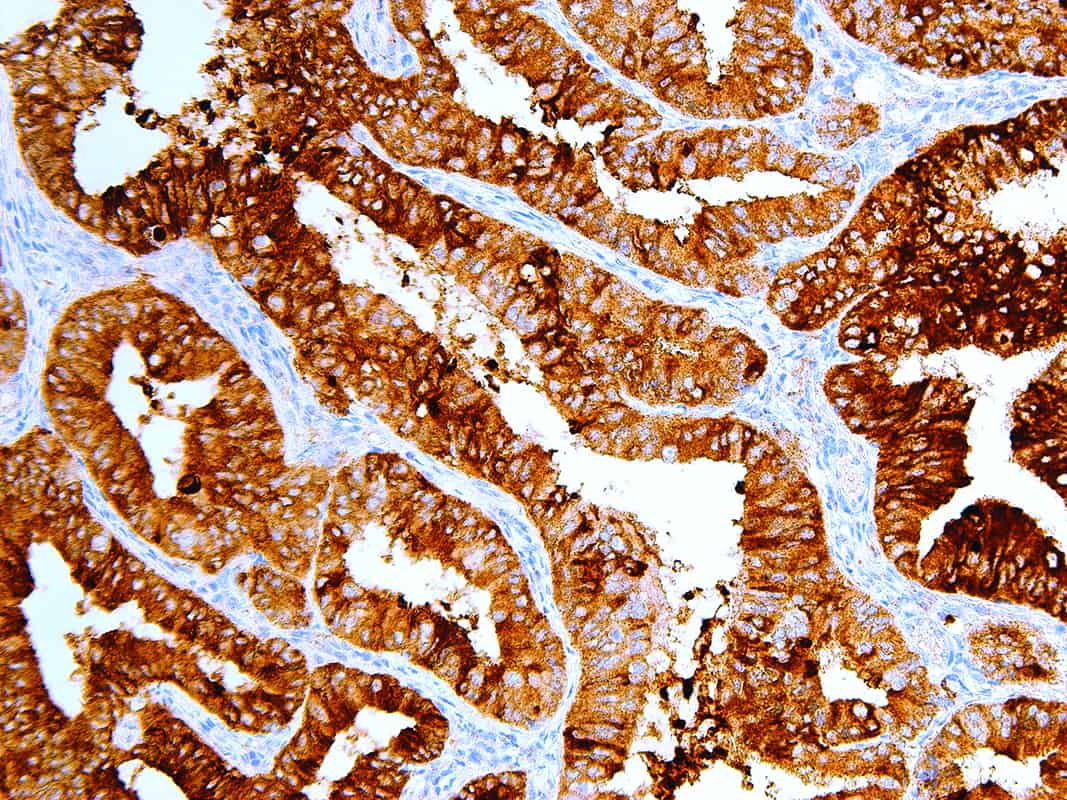
MUC1 | Medical Supply Company

MUC1
Mucin 1 (MUC1), also known as Epithelial Membrane Antigen (EMA), is a membrane-bound glycoprotein involved in a number of protective and cell-signaling functions, including cell-cell adhesion, proliferation, motility, invasion, and survival. Overexpression of MUC1 is clinically indicated in breast carcinomas, papillary thyroid carcinomas, and thymic carcinomas, and reports have named MUC1 as a useful marker for differentiating thymic carcinoma from type B3 thymoma. The expression of MUC1 is correlated with the grade of malignancy in thymic epithelial tumors, and loss of MUC1 expression has been associated with reactive gastropathy. MUC1 is not expressed in normal human epidermis, but has been detected in the epidermis of psoriatic plaques of biopsies from patients diagnosed with psoriasis vulgaris.
Specifications
| Clone | IHC623 |
| Source | Mouse Monoclonal |
| Positive Control | Breast, Colon, Associated Adenocarcinomas |
| Dilution Range | 1:50-1:200 |
Quantity
1.00
Select Volume
3 slides/package

Reviews
There are no reviews yet.